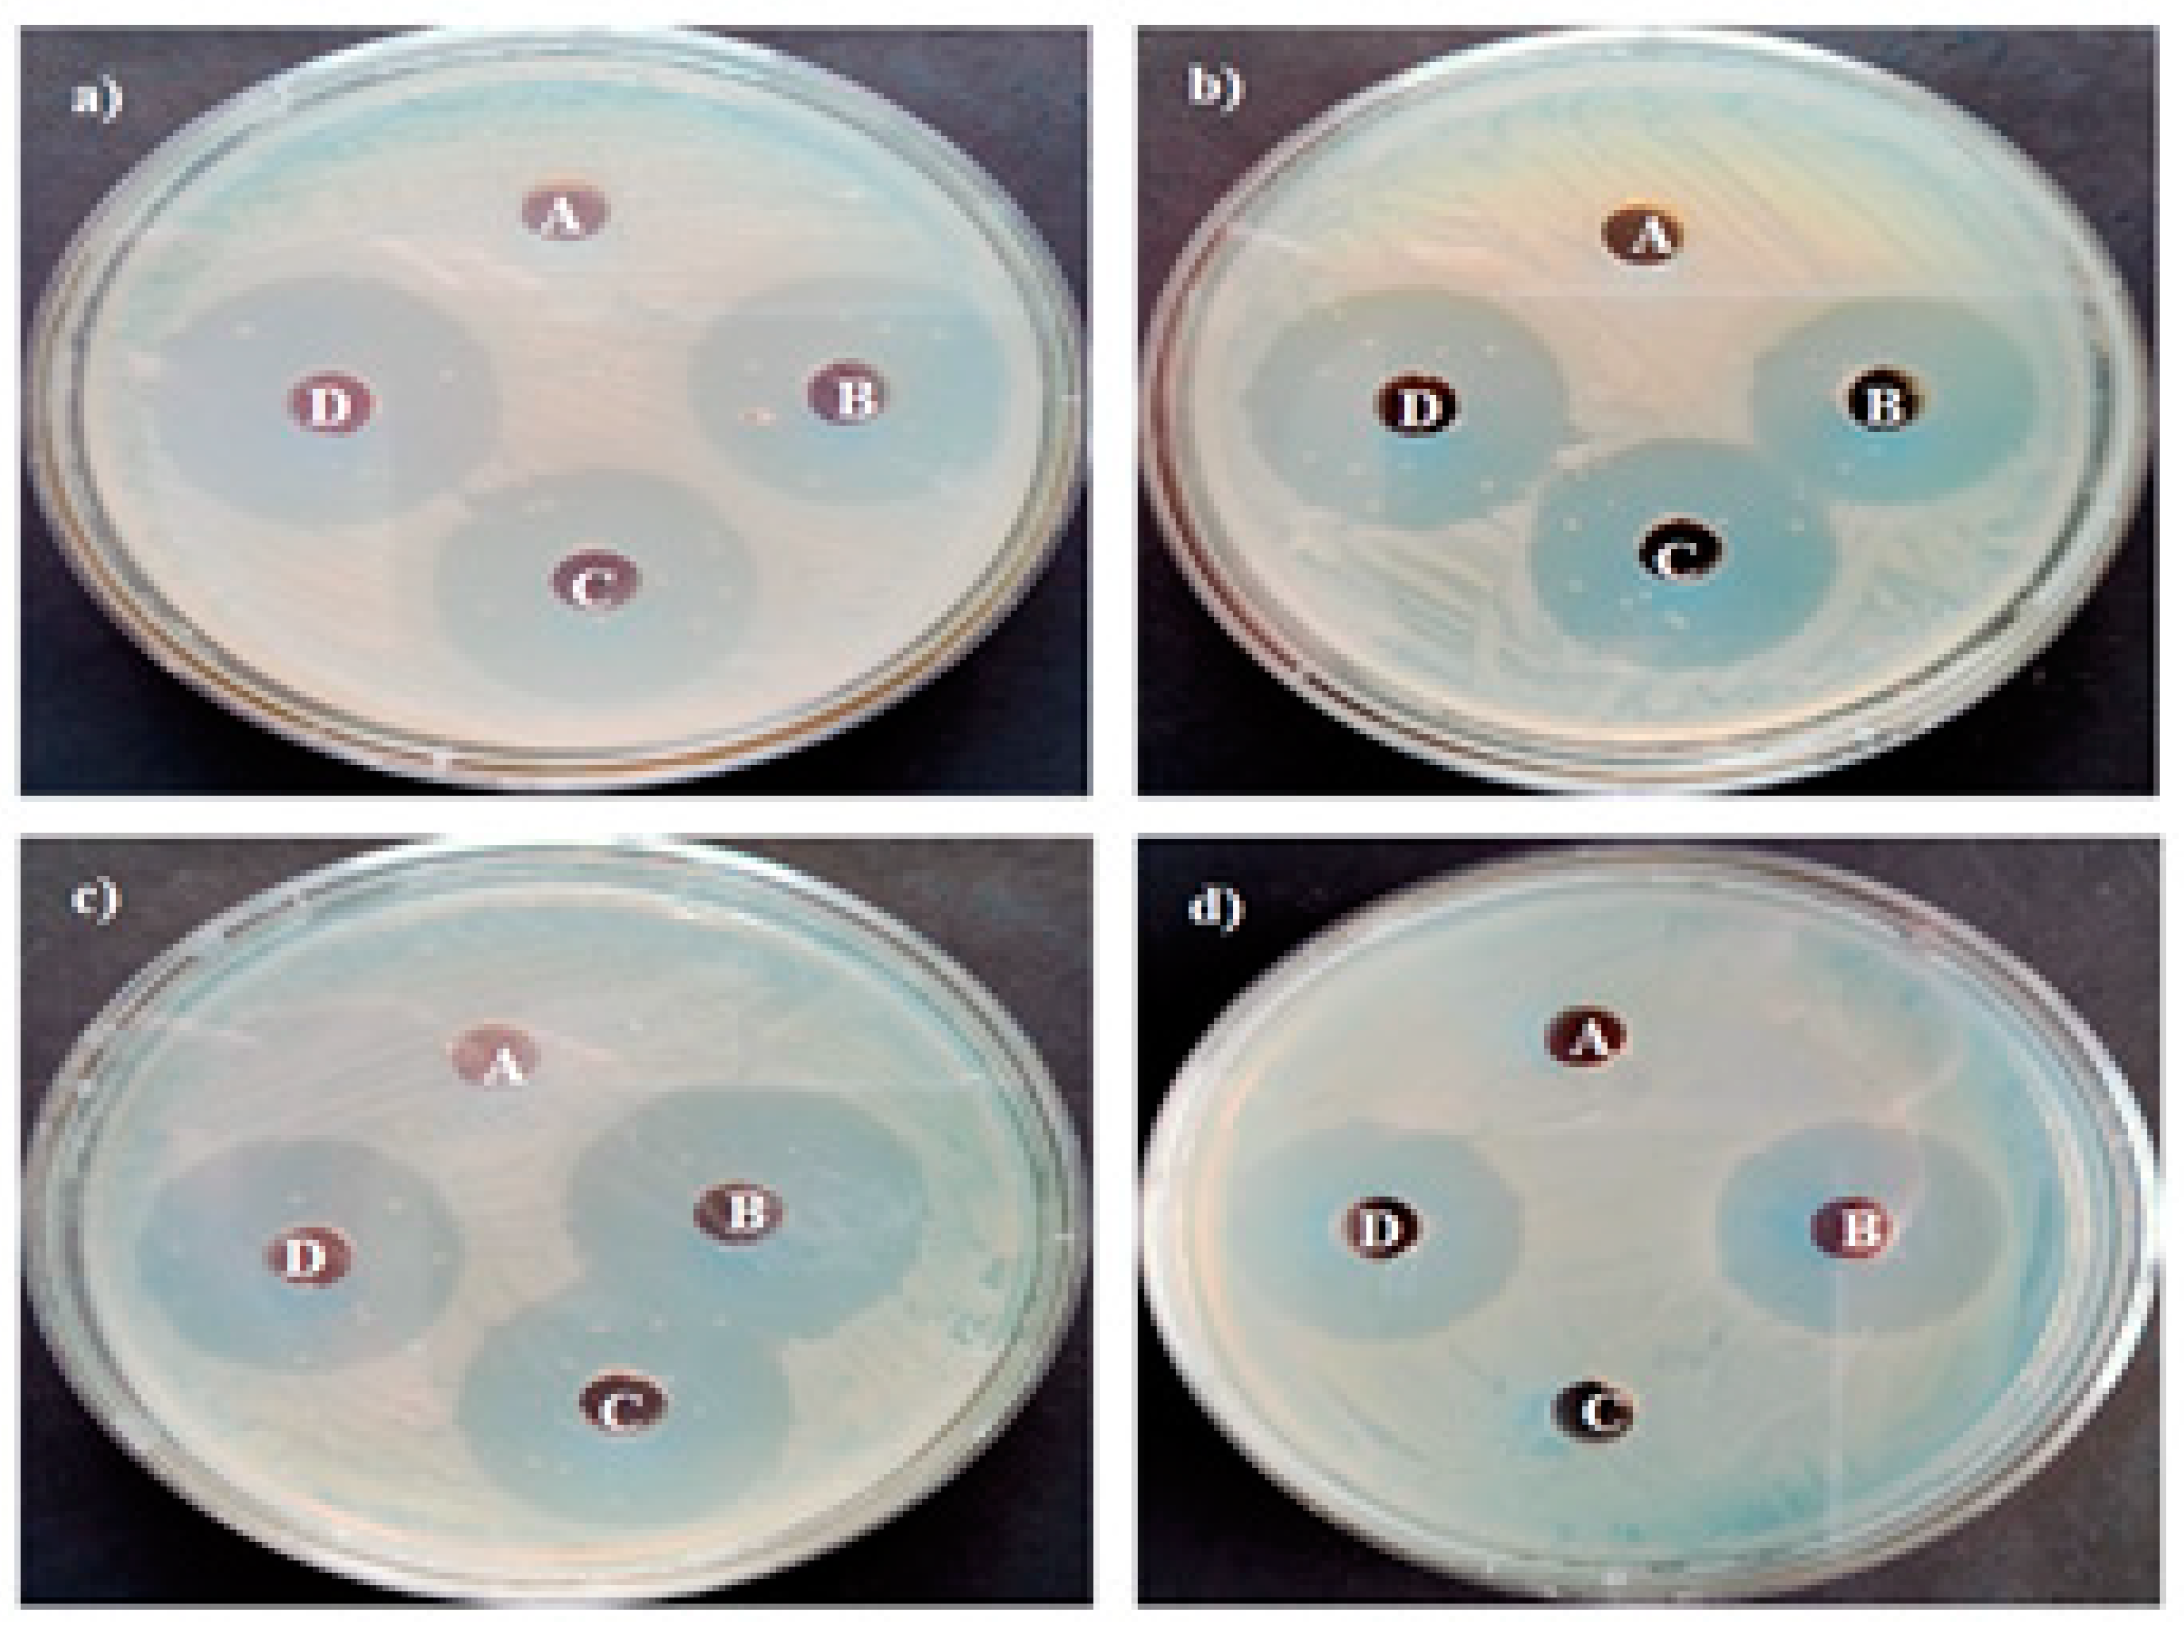
Bioengineering 10 00302 g012 Bioengineering 10 00302 g012

Green Synthesis of Magnesium Oxide Nanoparticles by Using Abrus precatorius Bark Extract and Their Photocatalytic, Antioxidant, Antibacterial, and Cytotoxicity Activities
Abstract
1. Introduction
2. Materials and Methods
2.1. Sample Preparation
2.2. Synthesis of MgO NPs
2.3. Characterization of MgO NPs
2.4. Photocatalytic Activity
2.5. Antioxidant Activity
2.6. Evaluation of in Vitro Toxicity
2.7. Cytotoxicity Evaluation
2.7.1. MTT Assay
2.7.2. XTT Assay
2.7.3. Neutral Red Uptake (NRU)
2.7.4. Lactase Dehydrogenase Release Assay
2.8. Genotoxic Evaluation
Comet Assay
2.9. Oxidative Stress Parameters
2.9.1. Determination of ROS
2.9.2. Measurement of Lipid Peroxidation
2.10. Antibacterial Activity
3. Results
3.1. Synthesis and Physico-Chemical Characterization of MgO NPs
3.2. Photocatalytic Activity
3.3. Antioxidant Activity
3.4. In Vitro Toxicity
3.5. Cytotoxic Evaluation
3.5.1. MTT Assay
3.5.2. XTT Assay
3.5.3. NRU Assay
3.5.4. LDH Release Assay
3.6. Genotoxic Assay
Comet Assay
3.7. Measurement of Oxidative Stress Parameters
3.7.1. Measurement of Intracellular ROS
3.7.2. Measurement of Lipid Peroxidation
3.8. Antimicrobial Activity
4. Conclusions
Author Contributions
Funding
Institutional Review Board Statement
Informed Consent Statement
Data Availability Statement
Acknowledgments
Conflicts of Interest
References
- Usher-Smith, J.A.; Emery, J.; Kassianos, A.P.; Walter, F.M. Risk prediction models for melanoma: A systematic review. Cancer Epidemiol. Biomark. Prev. 2014, 23, 1450–1463. [Google Scholar] [CrossRef] [PubMed]
- Kim, J.E.; Chung, B.Y.; Sim, C.Y.; Park, A.Y.; Lee, J.S.; Whang, K.U.; Park, Y.L.; Kim, H.O.; Park, C.W.; Lee, S.Y. Clinicopathologic features and prognostic factors of primary cutaneous melanoma: A multicenter study in Korea. J. Korean Med. Sci. 2019, 34, e126. [Google Scholar] [CrossRef]
- Smith, A.J.; Lambert, P.C.; Rutherford, M.J. Understanding the impact of sex and stage differences on melanoma cancer patient survival: A SEER-based study. Br. J. Cancer 2021, 124, 671–677. [Google Scholar] [CrossRef] [PubMed]
- Akter, M.; Sikder, M.T.; Rahman, M.M.; Ullah, A.K.M.A.; Hossain, K.F.B.; Banik, S.; Hosokawa, T.; Saito, T.; Kurasaki, M. A systematic review on silver nanoparticles-induced cytotoxicity: Physicochemical properties and perspectives. J. Adv. Res. 2018, 9, 1–16. [Google Scholar] [CrossRef] [PubMed]
- Khan, I.; Saeed, K.; Khan, L. Nanoparticles: Properties, applications and toxicities. Arab. J. Chem. 2019, 12, 908–931. [Google Scholar] [CrossRef]
- Mihai, M.M.; Dima, M.B.; Dima, B.; Holban, A.M. Nanomaterials for wound healing and infection control. Materials 2019, 12, 2176. [Google Scholar] [CrossRef]
- Choudhary, S.; Kumar, R.; Dalal, U.; Tomar, S.; Reddy, S.N. Green synthesis of nanometal impregnated biomass–antiviral potential. Mater. Sci. Eng. C 2020, 112, 110934. [Google Scholar] [CrossRef]
- Mageshwari, K.; Mali, S.S.; Sathyamoorthy, R.; Patil, P.S. Template-free synthesis of MgO nanoparticles for effective photocatalytic applications. Powder Technol. 2013, 249, 456–462. [Google Scholar] [CrossRef]
- Mohamed, S.A.; Prabhavathi, G.; Karunanithy, M.; Ayeshamariam, A.; Jayachandran, M. Green Synthesis of Nanoparticle by Plant Extracts-A New Aproach in Nanoscience. J. Bionanosci. 2018, 12, 401–407. [Google Scholar]
- Kouvaris, P.; Delimitis, A.; Zaspalis, V.; Papadopoulos, D.; Tsipas, S.A.; Michailidis, N. Green synthesis and characterization of silver nanoparticles produced using Arbutus unedo leaf extract. Mater. Lett. 2012, 76, 18–20. [Google Scholar] [CrossRef]
- De-Rui Di, M.E.; He, Z.-Z. A new nano-cryosurgical modality for tumor treatment using biodegradable MgO nanoparticles. Nanomed. Nanobiotechnol. 2012, 8, 1233–1241. [Google Scholar]
- Khan, F.S.A.; Mubarak, N.M.; Tan, Y.H.; Karri, R.R.; Khalid, M.; Walvekar, R.; Abdullah, E.C.; Mazari, S.A.; Nizamuddin, S. Magnetic nanoparticles incorporation into different substrates for dyes and heavy metals removal—A review. Environ. Sci. Pollut. Res. 2020, 27, 43526–43541. [Google Scholar]
- Chander, P.M.; Kartick, C.; Vijayachari, P. Medicinal Plants Used by the Nicobarese Inhabiting Little Nicobar Island of the Andaman and Nicobar Archipelago, India. J. Altern. Complement. Med. 2015, 21, 1–7. [Google Scholar] [CrossRef] [PubMed]
- Pandey, R.P.; Diwakar, P.G. An Integrated check- List flora of Andaman and Nicobar Islands, India. J. Econ. Taxon. Bot. 2015, 32, 403–500. [Google Scholar]
- Gupta, S.; Porwal, M.C.; Roy, P.S. Indigenous knowledge on some medicinal plants among the Nicobarese Tribals of Car Nicobar Islands. Indian J. Trad. Knowl. 2004, 3, 287–293. [Google Scholar]
- Sudha, K.G.; Ali, S.; Karunakaran, G.; Kowsalya, M.; Kolesnikov, E.; Rajeshkumar, M.P. Eco-friendly synthesis of ZnO nanorods using Cycas pschannae plant extract with excellent photocatalytic, antioxidant, and anticancer nanomedicine for lung cancer treatment. Appl. Organomet. Chem. 2020, 34, 5511. [Google Scholar] [CrossRef]
- Kushwaha, A.; Bagchi, T. MgONPs synthesis, capping and enhanced free radical effect on the bacteria and its cell morphology. AIP Conf. Prc. 2018, 1961, 10–11. [Google Scholar]
- Sudha, K.G.; Ali, S.; Karunakaran, G.; Kowsalya, M.; Kolesnikov, E.; Gorshenkove, M.V.; Rajeshkumar, M.P. An eco-friendly production of ZnO NRs using Knema andamanica (Warb) extracts for photocatalytic and anticancer applications. Inorg. Chem. Commun. 2021, 134, 109030. [Google Scholar] [CrossRef]
- Ali, S.; Sudha, K.G.; Karunakaran, G.; Kowsalya, M.; Kolesnikov, E.; Rajeshkumar, M.P. Green synthesis of stable antioxidant, anticancer and photocatalytic activity of zinc oxide nanorods from Leea asiatica leaf. J. Biotechnol. 2021, 329, 65–79. [Google Scholar] [CrossRef]
- Ali, S.; Sudha, K.G.; Karunakaran, G.; Kowsalya, M.; Kolesnikov, E.; Gorshenkove, M.V.; Rajeshkumar, M.P. Novel Leea grandifolia leaves mediated synthesis of ZnO nanorods for photocatalytic and anticancer applications. Appl. Organomet. Chem. 2021, 35, e6239. [Google Scholar] [CrossRef]
- Madhumitha, G.; Fowsiya, F.; Neelesh Gupta, A.; Kumar, M.; Singh, M. Green synthesis, characterization and antifungal and photocatalytic activity of Pithecellobium dulce peel–mediated ZnO nanoparticles. J. Phys. Chem. Solids 2019, 127, 43–51. [Google Scholar] [CrossRef]
- Fouda, A.; Hassan, S.E.D.; Saied, E.; Hamza, M.F. Photocatalytic degradation of real textile and tannery effluent using biosynthesized magnesium oxide nanoparticles (MgO-NPs), heavy metal adsorption, phytotoxicity, and antimicrobial activity. J. Environ. Chem. Eng. 2021, 9, 105346. [Google Scholar] [CrossRef]
- Serpen, A.; Capuano, E.; Fogliano, V.; Gokmen, V. A new procedure to measure the antioxidant activity of insoluble food components. J. Agric. Food Chem. 2007, 55, 7676–7681. [Google Scholar] [CrossRef] [PubMed]
- Sudha, K.G.; Ali, S.; Karunakaran, G.; Kowsalya, M.; Kolesnikov, E.; Gorshenkove, M.V.; Rajeshkumar, M.P. Cyrtrandroemia nicobarica-Synthesized ZnO NRs: A New Tool in Cancer Treatment. JOM 2021, 73, 364–372. [Google Scholar] [CrossRef]
- Bilberg, K.; Hovgaard, M.B.; Besenbacher, F. In vivo toxicity of silver nanoparticles and silver ions in zebrafish (Danio rerio). J. Toxicol. 2012, 2012, 293784. [Google Scholar] [CrossRef]
- Vasanth, K.; Ilango, K.; MohanKumar, R.; Agrawal, A.; Dubey, G.P. Anticancer activity of Moringa oleifera mediated silver nanoparticles on human cervical carcinoma cells by apoptosis induction. Colloids Surf. B Biointerfaces 2014, 117, 354–359. [Google Scholar] [CrossRef]
- Raghunandan, D.; Ravishankar, B.; Sharanbasava, G. Anti-cancer studies of noble metal nanoparticles synthesized using different plant extracts. Cancer Nanotechnol. 2011, 2, 57–65. [Google Scholar] [CrossRef]
- Suman, T.Y.; Rajasree, S.R.R.A.; Kanchana, S.B.; Elizabeth, B. Biosynthesis, characterization and cytotoxic effect of plant mediated silver nanoparticles using Morinda citrifolia root extract. Colloids Surf. B Biointerfaces 2013, 106, 74–78. [Google Scholar] [CrossRef]
- Kulandaivelu, B.; Gothandam, K.M. Cytotoxic effect on cancerous cell lines by biologically synthesized silver nanoparticles. Braz. Arch. Biol. Technol. 2016, 59, 23–29. [Google Scholar] [CrossRef]
- Gulsoy, N.; Yavas, C.; Mutlu, O. Genotoxic effects of boric acid and borax in zebrafish, Danio rerio using alkaline comet assay. EXCLI J. 2015, 14, 890–899. [Google Scholar]
- Yuan, R.; Xu, H.; Liu, X.; Tian, Y.; Li, C.; Chen, X.; Su, S.; Perelshtein, I.; Gedanken, A.; Lin, X. Zinc-doped copper oxide nanocomposites inhibit the growth of human cancer cells through reactive oxygen species-mediated NF-Κb activations. ACS Appl. Mater Interfaces 2016, 8, 31806–31812. [Google Scholar] [CrossRef] [PubMed]
- Tony, J.; Yiping, H. Antibacterial activities of magnesium oxide (MgO) nanoparticles against foodborne pathogens. J. Nanopart. Res. 2011, 13, 6877–6885. [Google Scholar]
- Pachiyappan, J.; Gnanansundaram, N.; Sivamani, S.; Pillai Sankari, N.P.B.; Senthilnathan, N.; Assefa Kerga, G. Preparation and Characterization of Magnesium Oxide Nanoparticles and Its Application for Photocatalytic Removal of Rhodamine B and Methylene Blue Dyes. J. Nanomater. 2022, 8, 124–128. [Google Scholar] [CrossRef]
- Palatino LinotypeKarunakaran, G.; Jagathambal, M.; Kumar, G.V.; Kolesnikov, E. Hylotelephium telephium flower extract mediated biosynthesis of CuO and ZnO nanoparticles with promising antioxidant and antibacterial properties for healthcare applications. JOM 2019, 72, 1264–1272. [Google Scholar]
- Asem, A.M.; Saad EL-Din, H.; Amr, F.; Mamdouh, S.E.; Salem, S.S. Extracellular Biosynthesis of Silver Nanoparticles Using Aspergillus sp. and Evaluation of their Antibacterial and Cytotoxicity. J. Appl. Life Sci. Int. 2017, 11, 1–12. [Google Scholar]
- Karunakaran, G.; Suriyaprabha, R.; Manivasakan, P.; Yuvakkumar, R.; Rajendran, V.; Kannan, N. Screening of in vitro cytotoxicity, antioxidant potential and bioactivity of nano-andmicro-ZrO2 and -TiO2 particles. Ecotoxicol. Environ. Saf. 2013, 93, 191–197. [Google Scholar] [CrossRef] [PubMed]
- Saikia, L.; Bhuyan, D.; Saikia, M.; Malakar, B.; Dutta, D.K.; Sengupta, P. Photocatalytic performance of ZnO nanomaterials for self sensitized degradation of malachite green dye under solar light. Appl. Catal. A Gen. 2015, 490, 42–49. [Google Scholar] [CrossRef]
- Shi, L.; Wang, F.; Wang, Y.; Wang, D.; Zhao, B.; Zhang, L.; Zhao, D.; Shen, D. Photoluminescence and photocatalytic properties of rhombohedral CuGaO2 nanoplates. Sci. Rep. 2016, 6, 21135. [Google Scholar] [CrossRef] [PubMed]
- Paul, S.; Saikia, J.P.; Samdarshi, S.K.; Konwar, B.K. Investigation of antioxidant property of iron oxide particlesby1′-1′diphenylpicryl-hydrazyle (DPPH) method. J. Magn. Magn. Mater. 2009, 321, 3621–3623. [Google Scholar] [CrossRef]
- Chang, J.S.; Chang, K.L.; Hwang, D.F.; Kong, Z.L. In vitro cytotoxicitiy of silica nanoparticles at high concentrations strongly depends on the metabolic activity type of the cell line. Environ. Sci. Technol. 2007, 41, 2064–2068. [Google Scholar] [CrossRef]
- Nan, A.; Bai, X.; Son, S.J.; Lee, S.B.; Ghandehari, H. Cellular uptake and cytotoxicity of silica nanotubes. Nano Lett. 2008, 8, 2150–2154. [Google Scholar] [CrossRef] [PubMed]
- Krishnamoorthy, K.; Moon, J.Y.; Hyun, H.B.; Cho, S.K.; Kim, S.J. Mechanistic investigation on the toxicity of MgO nanoparticles towards the cancer cells. J. Mater. Chem. 2012, 22, 24610–24617. [Google Scholar] [CrossRef]
- Ansari, Z.A.; Malhotra, B.D.; Ansari, S.J. Antibacterial and cytotoxic effect of magnesium oxide nanoparticles on bacterial and human cells. J. Nanoeng. Nanomanufact. 2013, 3, 162–166. [Google Scholar]
- Sinha, R.; El-Bayoumy, K. Apoptosis is a critical cellular event in cancer chemoprevention and chemotherapy by selenium compounds. Curr. Cancer Drug 2004, 4, 13–28. [Google Scholar] [CrossRef] [PubMed]
- El-Bayoumy, K.; Sinha, R. Mechanisms of mammary cancer chemoprevention by organoselenium compounds. Mutat. Res. 2004, 551, 181–197. [Google Scholar] [CrossRef] [PubMed]
- Lewinski, N.; Colvin, V.; Drezek, R. Cytotoxicity of nanoparticles. Small 2008, 4, 26–49. [Google Scholar] [CrossRef]
- Altıntıg, E.; Altundag, H.; Tuzen, M.; Sarı, A. Effective removal of methylene blue from aqueous solutions using magnetic loaded activated carbon as novel adsorbent. Chem. Eng. Res. Des. 2017, 122, 151–163. [Google Scholar] [CrossRef]
- Cha, Y.J.; Lee, J.; Choi, S.S. Apoptosis-mediated in vivo toxicity of hydroxylated fullerene nanoparticles in soil nematode Caenorhabditis elegans. Chemosphere 2012, 87, 49–54. [Google Scholar] [CrossRef]
- Lopez-Carrizales, K.I.; Montserrat, C.; Castillo, V. In vitro synergism of silver nanoparticles with antibiotics as an alternative treatment. Antibiotics 2018, 7, 50. [Google Scholar] [CrossRef]
- Guelfi, K.C.; Tognim, M.C.B.; Cardoso, C.L.; Gales, A.C.; Garcia, L.B.; Tognim, M.C.B.; Cardoso, C.L.; Gales, A.C. In vitro evaluation of the antimicrobial activity of meropenem in combination with polymyxin B and gatifloxacin against Pseudomonas aeruginosa and Acinetobacter baumannii in vitro evaluation of the antimicrobial activity of meropenem in combination with P. J. Chemother. 2013, 9478, 180–185. [Google Scholar]
- Park, E.J.; Yi, J.; Kim, Y.; Choi, K.; Park, K. Silver nanoparticles induce cytotoxicity by a Trojan-horse type mechanism. Toxicol. Vitr. 2010, 24, 872–878. [Google Scholar] [CrossRef] [PubMed]
- Remya, R.R.; Rajasree, S.R.R.L.; Aranganathan, R.; Suman, T.Y. An investigation on cytotoxic effect of bioactive AgNPs synthesized using Cassia fistula flower extract on breast cancer cell MCF-7. Biotechnol. Rep. 2015, 8, 110–115. [Google Scholar] [CrossRef]
- Li, H.; Chen, J.; Xiong, C.; Wei, H.; Yin, C.; Ruan, J. Apoptosis induction by the total flavonoids from Arachniodes exilis in HepG2 cells through reactive oxygen species-mediated mitochondrial dysfunction involving MAPK activation. Evid.-Based Complement. Altern. Med. 2014, 11, 2014. [Google Scholar]
- Khalil, A.T.; Ovais, M.; Ullah, I. Sageretia thea (Osbeck.) modulated biosynthesis of NiO nanoparticles and their in vitro pharmacognostic, antioxidant and cytotoxic potential. Artif. Cells Nanomed. Biotechnol. 2018, 46, 838–852. [Google Scholar] [CrossRef] [PubMed]
- Dobrucka, R.; Dlugaszewska, J.; Kaczmarek, M. Cytotoxic and antimicrobial effects of biosynthesized ZnO nanoparticles using of Chelidonium majus extract. Biomed. Microdev. 2017, 20, 5. [Google Scholar] [CrossRef] [PubMed]
- Izadiyan, Z. Cytotoxicity assay of biosynthesis gold nanoparticles mediated by walnut Juglans regia green husk extract. J. Mol. Struct. 2017, 97, 105. [Google Scholar] [CrossRef]
- Mehmood, S.; Hmed, W.; Ikram, M.; Lmtiaz, M.; Mahmood, S.; Shuxin Tu, A.; Chen, D. Chitosan modified biochar increase soybean (Glycine max L.) resistance to salt-stress by augmenting root morphology, antioxidant defense mechanism and the expression of sress response genes. Plants 2020, 9, 1173. [Google Scholar] [CrossRef]
- Ali, S.; Sudha, K.G.; Karunakaran, G.; Kowsalya, M.; Kolesnikov, E.; Gorshenkove, M.V.; Rajeshkumar, M.P. Anticancer and photocatalytic activities of zinc oxide nanorods synthesized from Manilkara littoralis leaf extract. Mater. Chem. Phys. 2022, 277, 125541. [Google Scholar] [CrossRef]
- Iravani, S. Green synthesis of metal nanoparticles using plants. Green. Chem. 2011, 13, 2368–2650. [Google Scholar] [CrossRef]
- Savoia, D. Plant-derived antimicrobial compounds: Alternatives to antibiotics. Future Microbiol. 2012, 7, 979–990. [Google Scholar] [CrossRef]
- Janaki, A.C.; Sailatha, E.; Gunasekaran, S. Synthesis, characteristics and antimicrobial activity of ZnO nanoparticles. Spectrochim. Acta A 2012, 144, 17–22. [Google Scholar] [CrossRef] [PubMed]
- Padmanabhan, V.P.; Sivashanmugam, P.; Kulandaivelu, R.; Sagadevan, S.; Sridevi, B.; Govindasamy, R.; Thiruvengadam, M. Biosynthesised Silver Nanoparticles Loading onto Biphasic Calcium Phosphate for Antibacterial and Bone Tissue Engineering Applications. Antibiotics 2022, 11, 1780. [Google Scholar] [CrossRef] [PubMed]
- Dikshit, P.K.; Kumar, J.; Das, A.K.; Sadhu, S.; Sharma, S.; Singh, S.; Gupta, P.K.; Kim, B.S. Green synthesis of metallic nanoparticles Applications and limitations. Catalysts 2021, 11, 902. [Google Scholar] [CrossRef]
- Dakal, T.C.; Kumar, A.; Majumdar, R.S.; Yadav, V. Mechanistic basis of antimicrobial actions of silver nanoparticles. Front. Microbiol. 2016, 7, 1831. [Google Scholar] [CrossRef]
- Tang, Z.X.; Lv, B.F. MgO nanoparticles as antibacterial agent: Preparation and activity. Braz. J. Chem. Eng. 2014, 31, 591–601. [Google Scholar] [CrossRef]
- Karunakaran, G.; Jagathambal, M.; Gusev, A.; Kolesnikov, E.; Mandal, A.R.; Kuznetsov, D. Allamanda cathartica flower aqueous mediated green synthesis of silver nanoparticles with excellent antioxidant and antibacterial potential for biomedical application. MRS Commun. 2016, 6, 41–46. [Google Scholar] [CrossRef]

| Concentration (µg/mL) | Antioxidant (%) | |
|---|---|---|
| Percentage of DPPH Inhibition (Absorbance 517 nm) | ||
| Ascorbic Acid | MgO NPs | |
| 20 | 11.66 | 15.8 |
| 40 | 19.93 | 32.33 |
| 60 | 32.33 | 43.16 |
| 80 | 38.16 | 46.2 |
| 100 | 51.00 | 56.06 |
| 120 | 60.86 | 65.93 |
| MgO NPs | Concentration (µg/mL) | Mortality (%) | ||||
| 24 h | 48 h | 72 h | 96 h | 120 h | ||
| Control | 0.2 ± 0.2 | 0.2 ± 0.4 | 0.3 ± 0.5 | 0.6 ± 0.6 | 0.1 ± 0.4 | |
| 20 | 1.2 ± 0.4 | 1.5 ± 0.3 | 1.7 ± 0.4 | 1.5 ± 0.5 | 0.0 ± 0.5 | |
| 40 | 0.1 ± 0.6 | 1.3 ± 0.2 | 2.8 ± 0.4 | 1.4 ± 0.9 | 0.0 ± 0.4 | |
| 60 | 1.0 ± 0.3 | 1.8 ± 0.4 | 3.9 ± 0.1 | 1.5 ± 0.3 | 0.0 ± 0.2 | |
| 80 | 0.1 ± 0.3 | 1.5 ± 0.8 | 1.6 ± 0.3 | 1.0 ± 0.2 | 0.0 ± 0.4 | |
| 100 | 0.2 ± 0.5 | 0.6 ± 0.7 | 1.3 ± 0.2 | 0.9 ± 0.1 | 0.0 ± 0.1 | |
| 120 | 0.1 ± 0.7 | 0.2 ± 0.3 | 1.0 ± 0.8 | 0.6 ± 0.5 | 0.0 ± 0.3 | |
| Concentration | ROS Generation (%) | Hydrogen Peroxide Concentration (n/mol) |
|---|---|---|
| Control | 100 ± 00 | 1.0 ± 0.9 |
| 20 µg/mL | 115 ± 0.1 | 1.5 ± 0.3 |
| 40 µg/mL | 129 ± 0.7 | 2.3 ± 0.6 |
| 60 µg/mL | 134 ± 0.5 | 3.4 ± 0.7 |
| 80 µg/mL | 143 ± 0.7 | 4.5 ± 0.2 |
| 100 µg/mL | 156 ± 0.5 | 5.6 ± 0.4 |
| 120 µg/mL | 161 ± 1.8 | 6.1 ± 0.9 |
| Microorganisms | Zone of Inhibition (Mean ± SD (mm)) | |||
|---|---|---|---|---|
| DMSO | Leaf Extract | MgO NPs | Standard Antibiotics | |
| S. epidermidis MTCC 2639 | -- | 10 ± 0.12 | 20 ± 0.26 | 20 ± 0.06 |
| B. subtilis MTCC 1133 | -- | 16 ± 0.30 | 31 ± 0.25 | 28 ± 0.99 |
| P. aeruginosa MTCC 2582 | -- | 12 ± 0.49 | 22 ± 0.50 | 21 ± 0.90 |
| E. coli MTCC 1692 | -- | 15 ± 0.01 | 30 ± 0.10 | 29 ± 0.89 |
Disclaimer/Publisher’s Note: The statements, opinions and data contained in all publications are solely those of the individual author(s) and contributor(s) and not of MDPI and/or the editor(s). MDPI and/or the editor(s) disclaim responsibility for any injury to people or property resulting from any ideas, methods, instructions or products referred to in the content. |
© 2023 by the authors. Licensee MDPI, Basel, Switzerland. This article is an open access article distributed under the terms and conditions of the Creative Commons Attribution (CC BY) license (https://creativecommons.org/licenses/by/4.0/).
Share and Cite
Ali, S.; Sudha, K.G.; Thirumalaivasan, N.; Ahamed, M.; Pandiaraj, S.; Rajeswari, V.D.; Vinayagam, Y.; Thiruvengadam, M.; Govindasamy, R. Green Synthesis of Magnesium Oxide Nanoparticles by Using Abrus precatorius Bark Extract and Their Photocatalytic, Antioxidant, Antibacterial, and Cytotoxicity Activities. Bioengineering 2023, 10, 302. https://doi.org/10.3390/bioengineering10030302
Ali S, Sudha KG, Thirumalaivasan N, Ahamed M, Pandiaraj S, Rajeswari VD, Vinayagam Y, Thiruvengadam M, Govindasamy R. Green Synthesis of Magnesium Oxide Nanoparticles by Using Abrus precatorius Bark Extract and Their Photocatalytic, Antioxidant, Antibacterial, and Cytotoxicity Activities. Bioengineering. 2023; 10(3):302. https://doi.org/10.3390/bioengineering10030302
Chicago/Turabian StyleAli, Saheb, Kattakgoundar Govindaraj Sudha, Natesan Thirumalaivasan, Maqusood Ahamed, Saravanan Pandiaraj, Vijayarangan Devi Rajeswari, Yamini Vinayagam, Muthu Thiruvengadam, and Rajakumar Govindasamy. 2023. "Green Synthesis of Magnesium Oxide Nanoparticles by Using Abrus precatorius Bark Extract and Their Photocatalytic, Antioxidant, Antibacterial, and Cytotoxicity Activities" Bioengineering 10, no. 3: 302. https://doi.org/10.3390/bioengineering10030302
APA StyleAli, S., Sudha, K. G., Thirumalaivasan, N., Ahamed, M., Pandiaraj, S., Rajeswari, V. D., Vinayagam, Y., Thiruvengadam, M., & Govindasamy, R. (2023). Green Synthesis of Magnesium Oxide Nanoparticles by Using Abrus precatorius Bark Extract and Their Photocatalytic, Antioxidant, Antibacterial, and Cytotoxicity Activities. Bioengineering, 10(3), 302. https://doi.org/10.3390/bioengineering10030302

